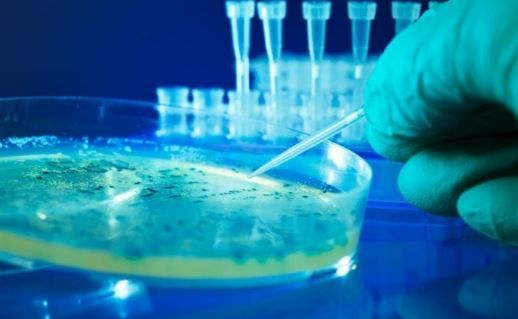

Επιστήμονες δημιούργησαν τους πρώτους ιούς που σχεδιάστηκαν από τεχνητή νοημοσύνη
Είναι ικανοί να εντοπίζουν και να καταστρέφουν στελέχη του βακτηρίου E. coli.
Ερευνητική ομάδα χρησιμοποίησε τεχνητή νοημοσύνη για να δημιουργήσει συνεκτικά ιογενή γονιδιώματα και στη συνέχεια τα χρησιμοποίησε για να συνθέσει βακτηριοφάγους ικανούς να σκοτώσουν ανθεκτικά στελέχη βακτηρίων.
«Αυτή είναι η πρώτη φορά που συστήματα τεχνητής νοημοσύνης μπορούν να γράψουν συνεκτικές αλληλουχίες σε επίπεδο γονιδιώματος. Το επόμενο βήμα είναι η ζωή που δημιουργείται από AI» αναφέρει ο Μπράιαν Χιε υπολογιστικός βιολόγος στο Πανεπιστήμιο του Στάνφορντ στην Καλιφόρνια, μέλος της ερευνητικής ομάδας που δημοσίευσε τη μελέτη της στο αρχείο επιστημονικών προδημοσιεύσεων bioRxiv και παρουσιάζει η ιστοσελίδα της επιθεώρησης «Nature».
Η ερευνητική ομάδα αναφέρει ότι η εργασία της δείχνει τις δυνατότητες της τεχνητής νοημοσύνης στο σχεδιασμό βιοτεχνολογικών εργαλείων και θεραπειών για τη θεραπεία βακτηριακών λοιμώξεων. «Ελπίζουμε ότι μια στρατηγική σαν αυτή μπορεί να συμπληρώσει τις υπάρχουσες στρατηγικές φαγοθεραπείας και κάποια μέρα να ενισχύσει τις θεραπείες για στοχευμένη αντιμετώπιση επικίνδυνων παθογόνων», λέει ο Χιε.
Γονιδιώματα από τον υπολογιστή
Μοντέλα τεχνητής νοημοσύνης έχουν ήδη χρησιμοποιηθεί για τη δημιουργία αλληλουχιών DNA μεμονωμένων πρωτεϊνών και πολυ-σύνθετων μοριακών συστημάτων. Ωστόσο, ο σχεδιασμός ολόκληρου γονιδιώματος είναι πολύ πιο απαιτητικός λόγω των πολύπλοκων αλληλεπιδράσεων μεταξύ των γονιδίων και των διαδικασιών αναπαραγωγής και ρύθμισης των γονιδίων. Αυτά τα συστήματα AI πλέον μπορούν να βοηθήσουν τους επιστήμονες να χειριστούν εξαιρετικά σύνθετα βιολογικά συστήματα, όπως ολόκληρα γονιδιώματα σύμφωνα με τους ερευνητές. «Υπάρχουν πολλές σημαντικές βιολογικές λειτουργίες που μπορείς να προσπελάσεις μόνο αν μπορείς να σχεδιάσεις πλήρη γονιδιώματα» λέει ο Χιε.
Για να σχεδιάσουν τα ιογενή γονιδιώματα, οι ερευνητές χρησιμοποίησαν τα μοντέλα AI Evo 1 και Evo 2, τα οποία αναλύουν και δημιουργούν αλληλουχίες DNA, RNA και πρωτεϊνών. Αρχικά, χρειάστηκαν ένα πρότυπο σχεδίασης, δηλαδή μια αρχική αλληλουχία που καθοδηγεί το μοντέλο AI να δημιουργήσει γονιδίωμα με επιθυμητά χαρακτηριστικά. Επέλεξαν τον ιό ΦΧ174, έναν απλό ιό με μονόκλωνο DNA που περιέχει 5,386 νουκλεοτίδια σε 11 γονίδια και όλα τα γενετικά στοιχεία που απαιτούνται για να μολύνει τους ξενιστές και να αναπαράγεται μέσα σε αυτούς.
Τα μοντέλα Evo είχαν ήδη εκπαιδευτεί σε πάνω από 2 εκατομμύρια γονιδιώματα φάγων (ειδική κατηγορία ιών που προσβάλλουν βακτήρια) αλλά οι ερευνητές τα εκπαίδευσαν περαιτέρω χρησιμοποιώντας μέθοδο εποπτευόμενης μάθησης για να δημιουργούν γονιδιώματα ιών τύπου ΦΧ174 με τη συγκεκριμένη λειτουργία να μολύνουν στελέχη E. coli, ιδιαίτερα εκείνα ανθεκτικά σε αντιβιοτικά.
Οι δοκιμές
Οι ερευνητές αξιολόγησαν χιλιάδες αλληλουχίες που παρήχθησαν από την τεχνητή νοημοσύνη και περιορίστηκαν σε 302 βιώσιμους βακτηριοφάγους. Οι περισσότεροι υποψήφιοι είχαν πάνω από 40% ταυτότητα νουκλεοτιδίων με τον ΦΧ174 ενώ κάποιοι είχαν εντελώς διαφορετικές αλληλουχίες κωδικοποίησης. Στη συνέχεια συνθέσαν DNA από τα AI σχεδιασμένα γονιδιώματα και τα εισήγαγαν σε βακτήρια-ξενιστές για να αναπτυχθούν οι φάγοι. Οι φάγοι αυτοί δοκιμάστηκαν πειραματικά για να διαπιστωθεί αν μπορούσαν να μολύνουν και να σκοτώσουν βακτήρια E. coli.
Από τους 302 AI-σχεδιασμένους βακτηριοφάγους, οι 16 έδειξαν εξειδίκευση για E. coli και μπόρεσαν να μολύνουν τα βακτήρια. Οι ερευνητές διαπίστωσαν ότι συνδυασμοί AI-σχεδιασμένων φάγων μπορούσαν να μολύνουν και να σκοτώσουν τρία διαφορετικά στελέχη E. coli, κάτι που ο φυσικός ΦΧ174 δεν μπορούσε να κάνει.
«Ήταν ένα αρκετά εντυπωσιακό αποτέλεσμα που μας ενθουσίασε, γιατί δείχνει ότι αυτή η μέθοδος μπορεί να είναι πολύ χρήσιμη για θεραπείες» λέει ο Σάμιουελ Κινγκ του Πανεπιστήμιου Στάνφορντ, μέλος της ερευνητικής ομάδας.
Naftemporiki.gr



